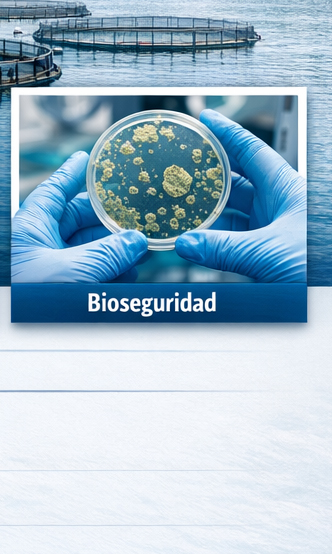
alphamar%20Servicios%20de%20desinfeccion%20de%20barcos%20y%20muelles

Termonebulizacion
Desinfectante viricida y bactericida de amplio espectro.
Servicio Garantizado
Profesionales capacitados

PISCICULTURAS
Servicios especializados en el diseño, planificación y ejecución de procesos de limpieza y desinfección para pisciculturas, adaptados a los más altos estándares de la industria acuícola..

LIMPIEZA DE TUBERÍAS EN SECO
Servicio especializado de limpieza de tuberías en seco, diseñado para eliminar residuos, incrustaciones y contaminantes sin el uso de líquidos, garantizando un proceso eficiente, seguro y respetuoso con los equipo.

TERMONEBULIZACIÓN
Termonebulización es un procedimiento avanzado de sanitización ambiental que garantiza la eliminación total de virus, s. Este método es especialmente efectivo contra el Coronavirus
PLANTAS DE PROCESO
Servicio realizado en terreno con el propósito de garantizar los más altos estándares de higiene industrial y bioseguridad en plantas procesadoras de salmón, durante los aseos operacionales (entre turnos) y los aseos de remate ).

DESOBSTRUCCIÓN Y LIMPIEZA DE MATRICES
Servicio especializado en desobstrucción y limpieza de matrices, diseñado para garantizar el óptimo funcionamiento de sistemas sanitarios e industriales, evitando obstrucciones, acumulación de residuos y fallas operativas.

INSPECCIÓN POR CÁMARAS DE TV
Inspección televisiva permite realizar un diagnóstico exacto y no invasivo del estado estructural y operativo de sus matrices o redes entregamos un respaldo completo con registro fotográfico y en video de alta resolución para una toma de decisiones informada
ALPHAMAR
Termonebulizacion
La desinfección por termonebulización es un procedimiento avanzado de sanitización ambiental que garantiza la eliminación total de virus, bacterias y patógenos en espacios cerrados. Este método es especialmente efectivo contra el Coronavirus y otros microorganismos, dejando un ambiente 100% seguro para el personal y los usuarios.

- Desinfectante viricida y bactericida de amplio espectro.
- Elimina patógenos en todas las superficies y el aire.
- Deja el ambiente libre de virus y bacterias de forma rápida y segura
- Proporciona mayor seguridad al personal y a los usuarios
-

Penetración Total
-

Gota 0.25 micras
-

Ambiente Seguro
ALPHAMAR
PISCICULTURAS
Ofrecemos servicios especializados en el diseño, planificación y ejecución de procesos de limpieza y desinfección para pisciculturas, adaptados a los más altos estándares de la industria acuícola. Nuestro enfoque se basa en procedimientos técnicos desarrollados por BioControl, los cuales son previamente revisados y aprobados por cada cliente, asegurando soluciones personalizadas, seguras y eficientes.
- Evaluación técnica de las instalaciones
- Diseño de planes de limpieza y desinfección.
- Ejecución de procesos con equipos especializados
- Cumplimiento de normativas sanitarias vigentes
-
Calidad
-
Seguridad
-
Control
ALPHAMAR
Somos especialistas en lo que hacemos
Especialización Marítima de Élite
01Expertos certificados bajo normas internacionales (IMO, DIRECTEMAR) para todo tipo de embarcaciones y terminales portuarios.
Tecnología Ecológica de Vanguardia
02Desinfección avanzada con ozono, UV-C y productos biodegradables que protegen el ecosistema marino.
Cumplimiento y Seguridad Global
03Garantía total en normativas sanitarias y fitosanitarias (ISPM 15), asegurando la operatividad ininterrumpida de su flota.
Contacto
Envienos sus consultas y que servicio requiere cotizar


